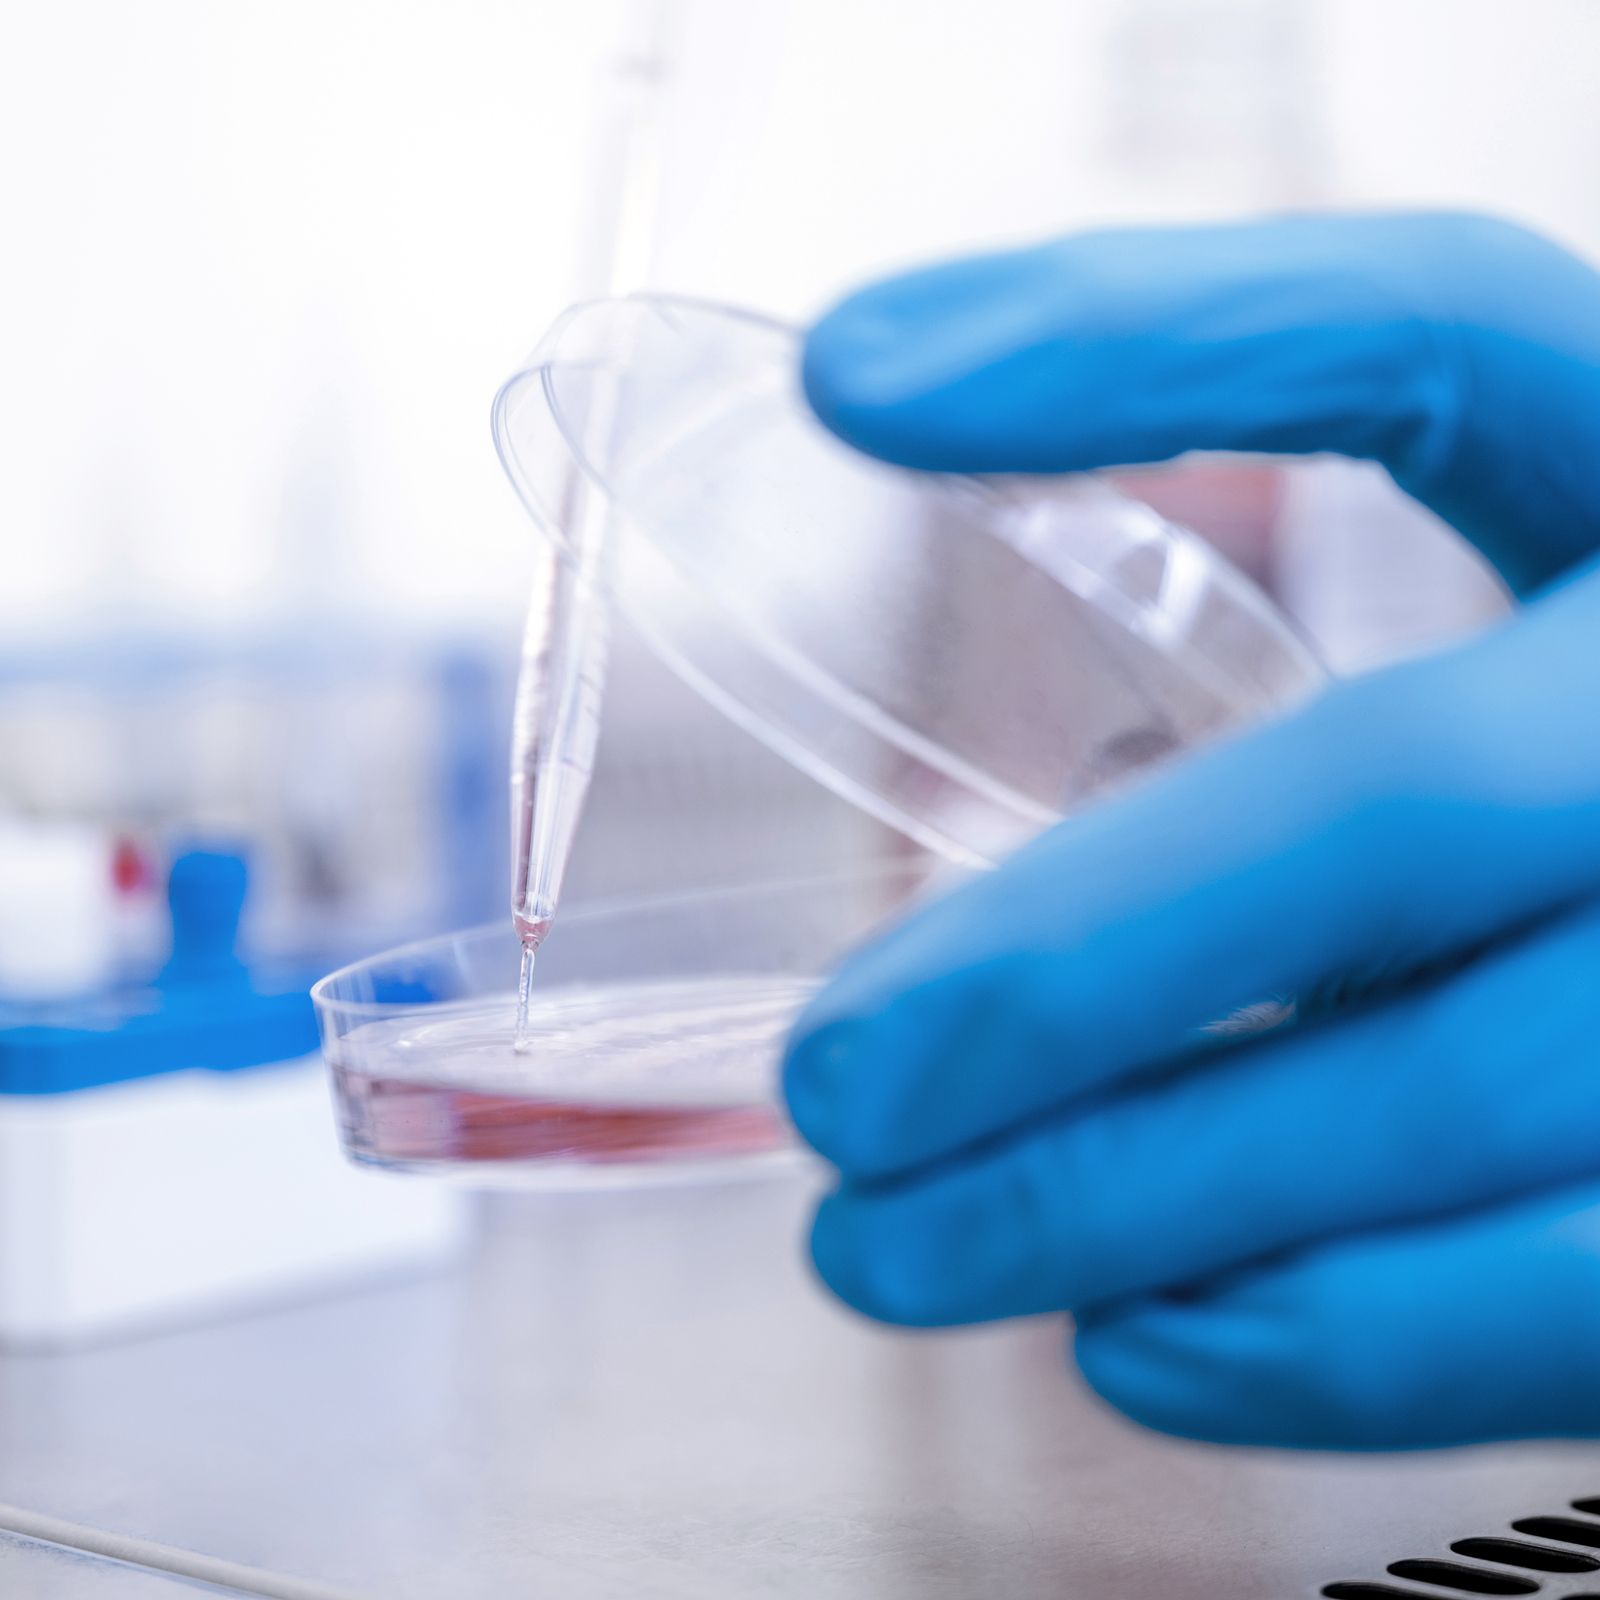

"Good Manufacturing Practice” regulations provide us with a system that should ensure consistent, controlled products and services. GMP stands for the best and safest services and products. The GMP guidelines include all aspects of the product’s life cycle and manufacturing process from product development and raw materials selection to the final production process, testing, storage, and shipment.
We are proud that we can offer such high-quality products for clinical work.







